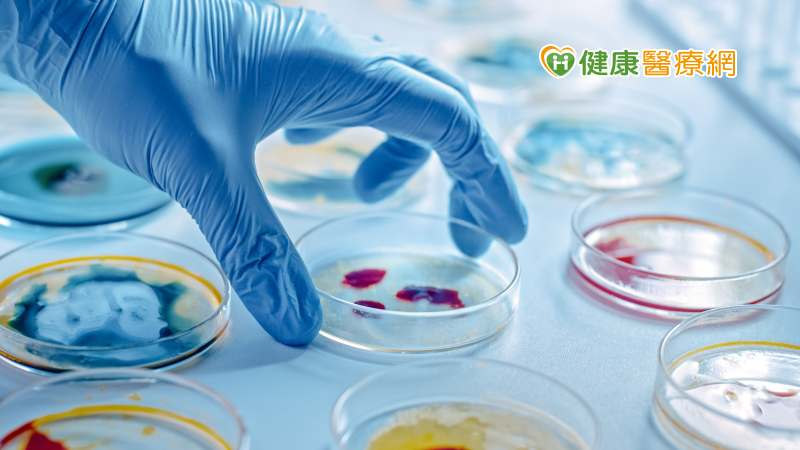
中國發現新蝙蝠冠狀病毒HKU5-CoV-2會感染人類細胞，研究發表於《Cell》期刊引起各界關注。（圖／示意圖）

近期,中國研究團隊在蝙蝠身上發現一種新的冠狀病毒「HKU5-CoV-2」可以感染人類細胞,引起國內外關注。許多人擔心是否會像COVID-19一樣造成大流行的疫情,對此疾管署發言人曾淑慧表示,病毒必須有3個特性才有造成大流行的可能,專家認為大流行的機會不大,不過仍要審慎評估。
HKU5-CoV-2可能人畜共通引關注 但為實驗室發現還需更多研究
中國武漢病毒研究所、廣州科學院、廣州實驗室在國際著名期刊《Cell》上發表了一項新的研究,引起各界關注。曾淑慧發言人說明,這個研究之所以會引起國際社會矚目,主要原因是他們發現蝙蝠的HKU5-CoV-2冠狀病毒細胞可以跟人類細胞結合,感染人類的呼吸道、腸胃道,因此認為這個病毒有可能會造成人畜共通疾病,甚至有可能會發生大流行。
由於之前造成大流行的傳染病疫情,包括中東呼吸道病毒(MERS-CoV)、SARS、新冠病毒等都是冠狀病毒,而且HKU5-CoV-2是從蝙蝠身上發現,又是由中國武漢實驗室團隊所進行的研究,所以不免讓人聯想到COVID-19疫情時期的經歷,擔心這樣的新冠狀病毒會讓新的疫情再起。
不過,曾淑慧發言人認為,由於這個研究主要還是在實驗室裡所進行的研究,是透過分子生物學的方法跟冷凍電子顯微鏡檢測技術來了解這個冠狀病毒細胞與人類細胞結合的狀況,會不會造成大流行或是造成人畜共通疾病仍然需要更多的研究。
大流行還需有3特性才有可能 後續須持續評估了解
此外,雖然HKU5-CoV-2和MERS-CoV、SARS、COVID-19一樣都是冠狀病毒,但曾淑慧發言人提到,MERS-CoV、SARS、COVID-19病毒之所以會造成新興傳染病的流行,除了能夠感染人類細胞以外,還有很重要的一個原因就是它們能夠在人體裡面進行複製,另外還有它們也能在人與人之間做傳播,而且更重要的是致病力,它們可能會造成心肺血管相關疾病,甚至造成重症、死亡,HKU5-CoV-2若有這幾個特性才有造成大流行的可能。
所以,世界衛生組織(WHO)相關專家認為HKU5-CoV-2造成大流行的機會不大。但曾淑慧發言人強調,目前仍然要審慎評估、了解HKU5-CoV-2這個病毒的研究進展,疾管署也會隨時進行相關風險評估。